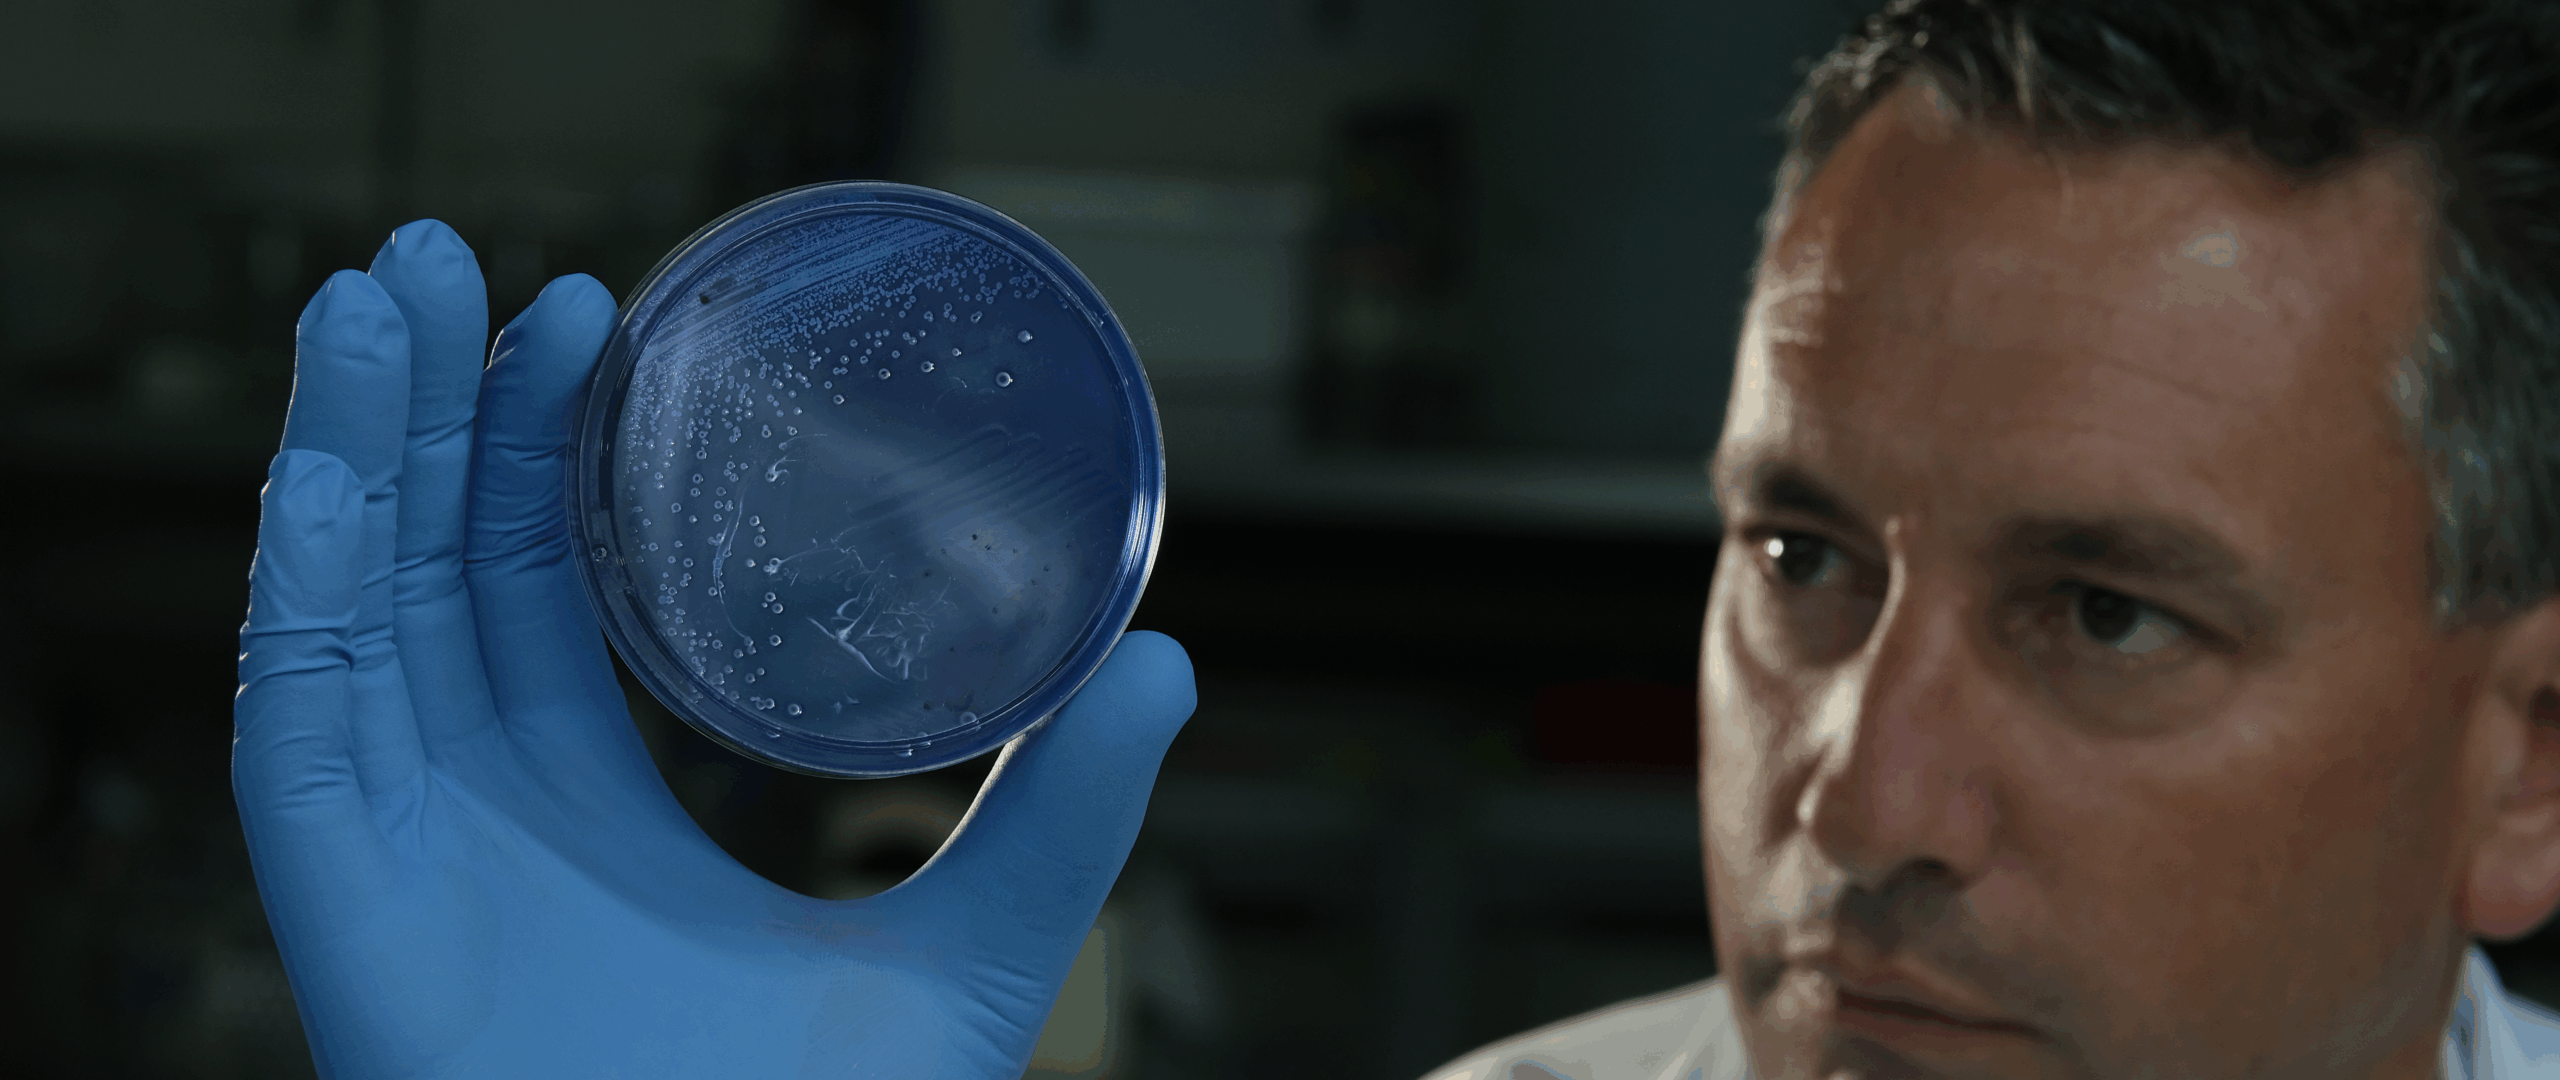

THIS WEBSITE IS FOR BUSINESS & INDUSTRY PARTNERS. FOR CONSUMER PRODUCTS VISIT : BLIS Probiotics >
THIS WEBSITE IS FOR BUSINESS & INDUSTRY PARTNERS. FOR CONSUMER PRODUCTS VISIT : BLIS Probiotics >
Explore our clinical studies to see why over 1 billion doses of BLIS® probiotics have been trusted globally.

BLIS Technologies is a global pioneer in oral probiotics.
Backed by more than 110 studies and 40+ clinical trials, our precision strains — including S. salivarius BLIS M18™ and S. salivarius BLIS K12™ — are proven to support immune health, fresh breath, and periodontal wellness.
Whether you’re in R&D, product development or regulatory, this is your shortcut to the science that sets BLIS apart.




Global Key Account Manager ENQUIRE NOW








